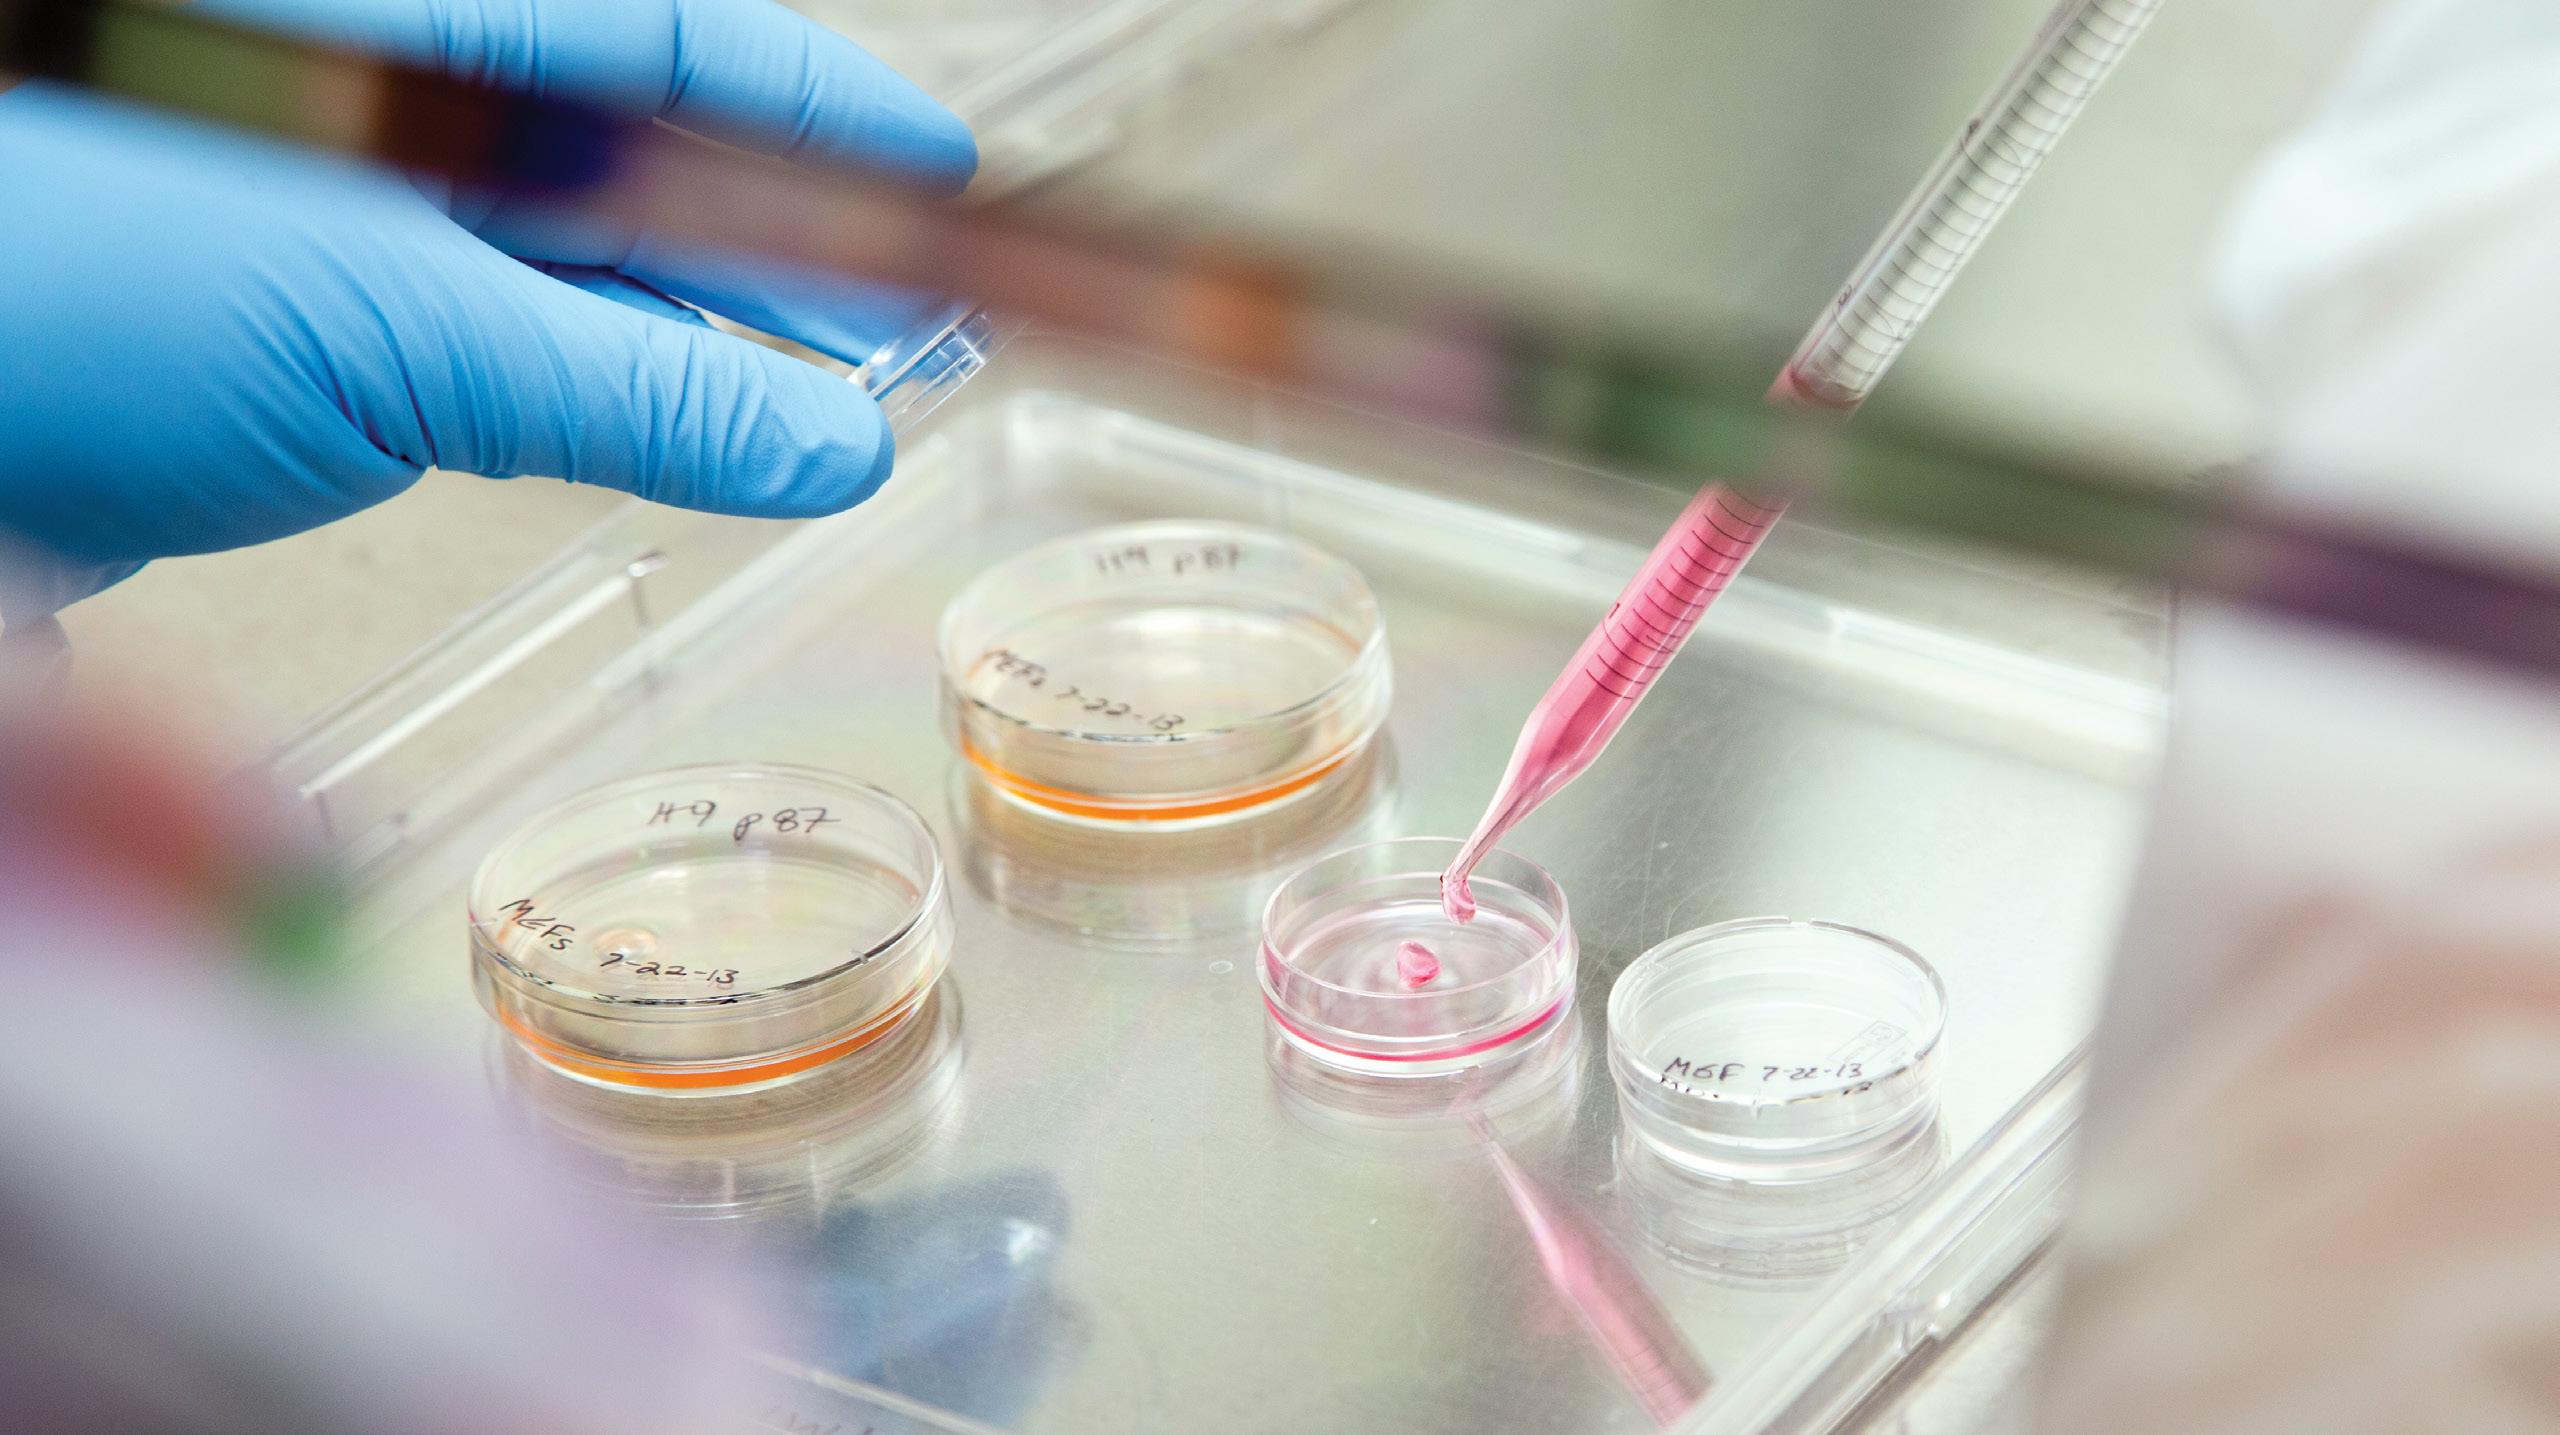

3 minute read
RESEARCH
The Frankel Cardiovascular Center has a vast research enterprise reliant on sound strategy to maximize efficiencies, quality, and research opportunities. The commitment to excellence through teamwork, innovation, caring, inclusion, and integrity is the basis for success for Frankel CVC Research Programs. Our goal is to generate new knowledge and make significant advances in cardiovascular research to lead the fight against cardiovascular disease.
Our commitment to basic science, translational and clinical research keeps us at the forefront of scientific discovery, demonstrates our leadership in the fight against cardiovascular disease and ensures patients have access to the expansive range of clinical research studies that are currently enrolling at the Frankel CVC.
There are currently 482 active research studies across 41 diverse divisions, departments, schools, and institutions at the University of Michigan.
RESEARCHERS AND CLINICIANS
The Frankel Cardiovascular Center recruits and retains promising scientists and clinicians who are not only successful in their fields, but who represent the Center’s mission, vision and values. Visit our digital timeline (med.umich.edu/ cvc/timeline/) to view the contributions of U-M cardiovascular researchers over the past 150+ years.
412 FACULTY MEMBERS
113 JOINT APPOINTMENTS
46 DIVISIONS, DEPARTMENTS, SCHOOLS, INSTITUTES
COLLABORATIVE PROGRAMS WITH LASER-FOCUSED RESEARCH GOALS
• M-BoCA* — work in understanding cardiovascular aging
• M-BRISC** — examining biological sex differences and their impact on cardiovascular health
• MI-AORTA*** — conducting aortic disease research in parallel with the clinical and educational aspects of this program
• MI-REACH**** — collaborative program in cardiovascular imaging
*Michigan Biology of Cardiovascular Aging Program
**Michigan Biological Research Initiative on Sex Differences in Cardiovascular Disease
***Multidisciplinary Aortic Program
**** Michigan Imaging – Research Education and Clinical Heart Program
RESEARCH EDUCATION
OPPORTUNITIES TO DISCUSS AND INSPIRE NEW DISCOVERIES
• Frontiers in Cardiovascular Science –Basic science content-focused seminar
• Cardiovascular and Cardiovascular Medicine Grand Rounds – Clinical science content-focused seminars
• C3RG* – Research staff education content-focused seminar
• SURF** – Basic science lab experience
• Frankel CVC Major Programs (MI-AORTA, M-BRISC, M-BoCA) – Monthly seminar series
*Cardiovascular Center Clinical Research Group
**Summer Undergraduate Research Fellowship
SUPPORTING INNOVATION
The Frankel Cardiovascular Innovation Program fosters a culture of innovation through education, funding, and mentorship for Frankel CVC faculty, staff, trainees, patients, and families. This aim empowers those within our ecosystem to create new or different systems and products that fundamentally change the existing system. The program is comprised of:
• Aikens Innovation Academy – A free, 10-week, virtual course on innovation and commercialization concepts available to cardiovascular innovators.
• Innovation Challenge – Annual pitch competition for those with cardiovascular innovations in the form of changes to patient care or potential new products compete for funding. “Just Do It” Awards are also available for low-cost, low-complexity ideas.
• Innovation Webinars and other educational offerings.
For more information, visit michmed.org/fcvcinnovation-program
BROAD OFFERING OF CLINICAL TRIAL OPPORTUNITIES
Clinical Trials Open to Enrollment FY24
110 TOTAL ACTIVELY ENROLLING CLINICAL TRIALS
DEDICATED RESOURCES TO FACILITATE RESEARCH SUCCESS
• CHIP*
• FCVC Cores**
• Regeneration Core Lab
• Shared cutting-edge research equipment inventory available to all CVC faculty
• Internal funding opportunities to launch discovery (more than $10M invested since 2013)
*Cardiovascular Health Improvement Project **Frankel Cardiovascular Center Core Laboratories
TECHNOLOGY TRANSFER LEADERS
Licensing agreements for CVC members –2007–2024
824 FILINGS (90 IN FY24)
418 ACTIVE (52 IN FY24)
80 LICENSED (11 IN FY24)
FOR MORE INFORMATION
Please email CVCVolunteer@med.umich.edu or visit UMHealthResearch.org for answers to your questions and additional information about our research programs.
Patients and their families can sign up to be matched with research studies for specific health conditions through UMHealthResearch.org, the greater University’s research community website.